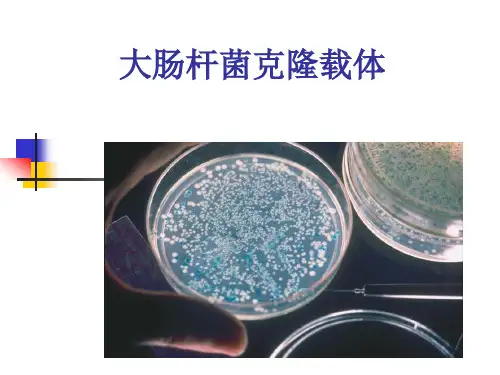

大肠杆菌分子克隆载体
- 格式:ppt
- 大小:827.00 KB
- 文档页数:42

为了让一个基因在Escherichia大肠杆菌中做它的事情,我们首先要做的就是创造一个超冷的表达矢量。
这个矢量需要有一个涡轮充电的促
进器来恢复基因的表达,同时需要有一个ribosome绑定的站点(RBS)来确保基因像老板一样被翻译出来。
嘿,我们不能忘记一个
选择标记,像抗生素抗体基因,所以我们可以挑出细菌已经提取了
载体。
塞恩斯是真正有趣的部分——我们利用一些精致的分子克隆技术,把感兴趣的基因弹入载体中,比如用限制酶切开,然后像一个基
因谜题一样将其重新粘合起来。
对于一些细菌生物学刺激来说如何?
将表达矢量组合起来后,要通过变换等过程,将其粘入E。
coli细胞。
你用正确的抗生素将转化出来的细菌生长在藻类板上。
这使得只有
具有表达载体的细菌才能存活。
一旦你选择了细菌,你就抓住一个单
一的聚落,用它开始一个液体培养。
你让培养物生长到有很多细胞,
然后你可以打开你感兴趣的基因。
E。
coli基因表达的诱导是推进基因研究和生物技术创新的关键步骤。
必须根据表达矢量中使用的具体促进器,仔细选择适当的诱导器,因
为各种促导器对不同的诱导器表现出不同的反应。
在加入诱导物后,
培养物会受到指定孵化期的制约,以方便被利益基因编码的蛋白质的
合成。
在诱导过程之后,细菌被收获,通过SDS—PAGE,西部布局,酶活性测定等方法,彻底检查基因表达水平。
这些精心规划和执行的
实验使研究人员能够全面评估E。
大肠杆菌蛋白质产量的定量和定性方
面,从而为遗传工程和工业生物技术领域今后的研究和政策决定提供信息。


基因工程所用的克隆载体常称之为分子克隆载体(molecular cloning vector),它是一类可供外源DNA插入并携带重组DNA分子进入适当宿主细胞的DNA分子。
如果打一个十分浅显的比喻,分子克隆载体犹如航天技术中的运载火箭,外源DNA分子就如火箭上搭载的卫星,宿主细胞则如外部深邃的空间。
分子克隆载体的主要功能就是将外源基因携带入宿主细胞,并在宿主细胞中进行DNA扩增和使外源基因得以高效表达。
在这一点上又与火箭不一样,因为火箭在运载卫星的过程中分级脱落和烧毁。
尽管克隆载体是由DNA分子所构成,但与宿主细胞的染色体DNA分子相比,它们一般都比较小。
比如常用的质粒载体多数都在10 kb以下,而常用的噬菌体载体,一般都在20 kb 左右。
我们知道,大肠杆菌的染色体DNA是4200kb。
正是由于克隆载体的分子量比较小,在操作过程中不会造成载体DNA分子的断裂,而大分子的DNA容易在操作中发生断裂。
克隆载体的基本结构和功能在短短的20年间,用于不同生物和不同目的的分子克隆载体至少也有好几千种,那么它们应该有些什么样的基本结构呢?经过仔细分析发现,所有的分子克隆载体都具备了以下3个最基本的结构:1)至少有一个复制起点,因而至少可在一种生物体中自主复制;2)至少应有一个克隆位点,以供外源DNA插入;3)至少应有一个遗传标记基因,以指示载体或重组DNA 分子是否进入宿主细胞。
既然说每一个载体至少应有一个复制起点,一个克隆位点和一个标记基因,那么一个载体可否有多个复制起点,多个克隆位点和多个标记基因呢?答案是肯定的。
不过,我们还是先看看载体中的三个基本结构克隆载体的复制起点由于DNA的复制是始于复制起点的,因此只要一个DNA分子有了复制起点,那么这个DNA分子就可以自主复制。
如果一个分子克隆载体有了复制起点,那么该载体就可以在某种生物的细胞中自主复制,因此这个载体就可以多拷贝地存在于某种细胞内。
多拷贝DNA有两个好处:一是可以用于大量制备克隆载体DNA分子,以利于外源基因的克隆,这样可大大减少工作量;二是如果载体中插入了外源基因,那么外源基因的拷贝数也就大量增加了,这就有利于大量地表达外源基因,从而获得大量的基因表达产物,这也正是基因工程的目的之一。

分子克隆技术的使用方法分子克隆技术是在分子生物学领域中最常用的一种实验方法,它可以帮助研究人员复制并分离出特定的DNA序列,用于进一步研究和应用。
分子克隆技术的使用方法主要包括DNA提取、限制性内切酶切割、连接反应、转化和筛选等步骤。
下面将对这些步骤逐一进行介绍。
首先,DNA提取是分子克隆技术的第一步,它的目的是从样品(例如细菌、植物或动物组织)中提取出目标DNA。
提取方法主要有酚/氯仿法、盐法和商用DNA提取试剂盒等。
在提取过程中,我们需要将样品细胞破裂,并通过使用蛋白酶分解蛋白质,最后通过乙酸盐、异丙醇等溶剂沉淀目标DNA。
其次,限制性内切酶是分子克隆技术中的关键工具,它能够识别并切割DNA 的特定序列。
在实验中,我们选择与目标DNA序列相匹配的限制性内切酶,将其与目标DNA一起反应,酶可以精确切割DNA链,产生特定的末端序列。
这样的切割可以生成需要的DNA片段用于后续的连接反应。
连接反应是分子克隆技术的核心步骤,通过该步骤可以将目标DNA片段与载体DNA连接起来。
通常情况下,载体DNA是一种循环的DNA分子,如质粒或噬菌体。
在连接反应中,我们需要将目标DNA片段与已经经过限制性内切酶切割处理的载体DNA进行连接。
连接反应可以使用DNA连接酶和缓冲液,在适当的温度下进行反应。
连接反应的最终产物是重组载体,内含目标DNA的插入片段。
然后,转化是将重组载体导入到宿主细胞中的过程。
对于大多数分子克隆实验来说,大肠杆菌是最常见的宿主细胞。
在转化过程中,我们需要将重组载体与宿主细胞共同处理,使其能够进入细胞内。
转化方法主要有热激、电击和化学法等。
通过转化,重组载体可以复制并表达其携带的目标DNA片段。
最后,筛选是分子克隆技术中的关键步骤,它可以确定是否成功克隆了目标DNA片段。
筛选依赖于所克隆目标的特性和选择的标记方法。
常用的筛选方法包括酶切鉴定、PCR扩增、限制性酶切图谱分析以及DNA序列分析等。
这些方法可以帮助我们鉴定和验证克隆的目标DNA片段是否符合预期。

分子克隆技术实验报告姓名:班级:学号:指导老师:pUC19外源1.5kbDNA片段亚克隆于pUC1301摘要:分别从大肠杆菌菌液中提取质粒pUC19和pUC1301,两种质粒都使用Bam HI+Kpn I两种限制性内切酶进行切割。
回收pUC1301质粒中1.5kb片段,使用连接酶将它与切开的pUC19连接,转化感受态大肠杆菌,利用标记基因amp r、kan r和α—互补筛选阳性克隆。
实验获得了很好的酶切效果,但最后没有筛选出阳性克隆。
关键词:pUC19、pUC1301、亚克隆、限制性内切酶、感受态1前言初始克隆中的外源DNA片段往往较大,含有许多目的基因以外的片段,在诸如表达、序列标签和突变等操作中不变进行,因此必须将目的基因所对应的小片段DNA找出来,这个过程叫做亚克隆。
本实验是将pU1301中一段来自水稻1.5kb的片段亚克隆到pUC19上。
首先需要提取所需的质粒。
在大肠杆菌中质粒又大又小、拷贝数又多又要少,因此分离的方法也多种多样。
在实践中最常见的是通过将裂解法提取高拷贝的小质粒以及基于此方法的纯化技术,其他方法还有试剂盒分离纯化等,本实验通过试剂盒分离纯化E.coil质粒DNA。
将质粒提取出来后需要检测所获质粒的质量,方法有吸光值检测、凝胶电泳检测等。
要获得目的片段然后亚克隆与其他载体上,需使用两种工具酶:限制性内切酶、连接酶。
限制性酶切酶主要有三类,目前使用最多的是Ⅱ型。
限制性内切酶的使用需要在合适的条件下,当条件不合适时往往会出现星星活性。
限制性内切酶产生的黏性末端将导致载体自连,为了防止其自连,可以使用双酶切、去磷酸化、末端补平等方法。
连接酶是将两段核酸连接起来的酶,常用的有T4DNA连接酶、大肠杆菌DNA连接酶、TaqDNA连接酶、T4RNA连接酶。
目的片段和载体在连接酶作用下连接成一个整体,需借助一定方法导入受体细胞,首先需要制备感受态细胞,这类细胞处在易吸收外源DNA 条件下,然后通过电转化、CaCl2转化法将外源DNA导入受体细胞。

escherichia coli k12过表达-回复如何在大肠杆菌K12中过表达目标蛋白。
引言:大肠杆菌(K12)是常见的实验室模型菌株之一,广泛应用于分子生物学和生物工程研究领域。
过表达外源蛋白是研究蛋白功能和生物过程的重要手段之一。
本文将介绍如何在大肠杆菌K12中进行过表达,并提供详细的步骤和相关技术。
第一部分:构建过表达载体1. 选择合适的表达载体:选择适合大肠杆菌K12的表达载体,常见的包括pET系列和pBAD系列。
根据需求选择合适的启动子、选择抗生素耐药基因等。
2. 克隆目标基因:使用标准的分子克隆技术,将目标基因插入表达载体的多克隆位点(MCS)上,确保正确的定向和插入。
3. 验证重组载体:通过限制性内切酶酶切和测序等方法,验证克隆成功的重组载体,确保目标基因的正确插入。
第二部分:转化大肠杆菌1. 准备化学竞争性转化试剂(如CaCl2):将大肠杆菌K12 试管预培养在含有适当抗生素的LB培养基中,30C静置过夜,或在37C上摇培养2-4小时。
2. 收获菌液:从预培养的菌液中取适量菌液,通过离心将细胞沉淀,并用LB培养基中的胞质液重悬滞液沉淀。
3. 转化:将化学转化试剂添加到胞质液中,进行热突变,使得大肠杆菌细胞获得质粒的能力。
然后将转化液在37C孵育60-90分钟,再在冰上孵育10分钟。
4. 表达抗生素抗性:将转化后的菌液均匀涂布在含有抗生素的培养基上,并在37C下培养过夜,以筛选抗生素抗性阳性菌落。
第三部分:过表达蛋白1. 前处理:将含有抗生素阳性菌落的菌液接种到含有适量抗生素的LB培养基中,培养至适当的菌液浓度(通常为OD600约为0.5-0.8)。
2. 诱导表达:加入适当浓度的诱导剂,如IPTG,诱导目标基因的表达。
培养条件如温度、培养时间、诱导剂浓度等根据实验需求进行调整。
3. 培养和收获蛋白:在适当的温度和时间下继续培养大肠杆菌,通常在30C或37C下进行培养。
通过离心将细胞沉淀并收取,然后通过超新星破碎细胞壁,释放目标蛋白。

三四章分⼦克隆载体---答案_完_第三章分⼦克隆载体(Molecular cloning vectors)⼀、名词解析1.质粒:质粒是染⾊体外的遗传因⼦,能进⾏⾃我复制(但依赖于宿主编码的酶和蛋⽩质);⼤多数为超螺旋的双链共价闭合环状DNA分⼦(covalently closed circle , cccDNA),少数为线性;⼤⼩⼀般为1~200Kb,有的更⼤。
2.质粒拷贝数:质粒拷贝数(plasmid copy numbers)是指细胞中单⼀质粒的份数同染⾊体数之⽐值,常⽤质粒数/每染⾊体来表⽰。
不同的质粒在宿主细胞中的拷贝数不同。
3.质粒的不相容性:两个质粒在同⼀宿主中不能共存的现象称质粒的不相容性,它是指在第⼆个质粒导⼊后,在不涉及DNA 限制系统时出现的现象。
不相容的质粒⼀般都利⽤同⼀复制系统,从⽽导致不能共存于同⼀宿主中。
4.质粒的转移性:质粒具转移性。
它是指在⾃然条件下,很多质粒可以通过称为细菌接合的作⽤转移到新宿主内。
它需要移动基因 mob ,转移基因 tra ,顺式因⼦ bom 及其内部的转移缺⼝位点 nic。
5.穿梭质粒:既能在真核细胞中繁殖⼜能在原核细胞中繁殖的载体。
这类载体必须既有细菌的复制原点或质粒的复制原点,⼜含有真核⽣物的复制原点,还具备酶切位点和合适的筛选指标。
它⽤来转化细菌,⼜可以⽤于转化真核细胞。
6.α-互补:α-互补是指 lacZ 基因上缺失近操纵基因区段的突变体与带有完整的近操纵基因区段的β-半乳糖苷酶(β -galactosidase ,由 1024 个氨基酸组成)阴性的突变体之间实现互补。
α-互补是基于在两个不同的缺陷β-半乳糖苷酶之间可实现功能互补⽽建⽴的7.温和噬菌体:既能进⼊溶菌⽣命周期⼜能进⼊溶源⽣命周期的噬菌体。
8.溶源性细菌:具有⼀套完整的噬菌体基因组的细菌叫溶源性细菌。
9.整合:如果噬菌体的DNA是被包容在寄主细菌染⾊体DNA中,便叫做已整合的噬菌体DNA。

如何构建一个大肠杆菌高效表达的分子克隆?影响基因在大肠杆菌中表达的因素是多方面的,以下我就从载体选择、启动子、终止子、核糖体结合位点、密码子、质粒拷贝数、表达产物的稳定性、受体细胞代谢等方面说明构建大肠杆菌高效表达的方法。
一、表达载体表达载体应具有以下条件:1、能够独立复制。
根据载体复制的特点,可分为严谨型和松弛型。
严谨型载体伴随宿主染色体的复制而复制,在宿主中拷贝数很少(1~3个);松弛型的复制而不依赖于宿主染色体,在宿主细胞中的拷贝数可多达3000个。
2、应具有灵活得多克隆位点和方便的筛选标记,便于外源基因的克隆、鉴定和筛选。
而且多克隆位点应位于启动子序列之后,以使外源基因表达。
3、应具有很强的启动子,能被大肠杆菌的RNA聚合酶识别。
4、应具有使启动子受抑制的阻遏子,只有在受到诱导时才能进行转录。
阻遏子的阻遏作用可由物理(如温度)、化学(如IPTG、IAA等)因素进行调节,这样可人为地选择启动子启动转录mRNA的时机。
因外源基因的高效表达往往会抑制宿主细胞的生长、增殖。
而阻遏子可使宿主细胞免除此不良影响。
例如可使宿主细胞快速生长增殖到相当量,再通过瞬时消除阻遏,使所表达的蛋白质在短时间内大量积累,同时可减少表达产物的降解。
5、应具有很强的终止子,以便使RNA聚合酶集中力量转录克隆的外源基因,而不转录其他无关基因。
同时强终止子所产生的mRNA较为稳定。
诱导表达时,由于强终止子所致的高水平转录反过来会影响质粒DNA自身的复制,从而引起质粒的不稳定或脱质粒现象。
因此在外源基因的下游安置强终止子可以克服由质粒转录引起的质粒不稳定。
6、所产生的mRNA必须有翻译的起始信号,即起始密码AUG和SD序列。
二、启动子启动子是表达载体最重要的组成成分,这是因为启动子控制了基因表达的第一个阶段,决定了mRNA合成的速度。
启动子是在转录水平上影响基因表达。
转录的最大速率取决于启动子中碱基的组成,往往会因为一个碱基的不同,启动子效率可能提高上千倍。

1 实验概述分子生物学试验指导1 实验概述1.1 实验目的实验过程中, 主要通过碱裂解法提取质粒DNA.对质粒进行双酶切、并连接构建成重组DNA分子、大肠杆菌DH5α感受态细胞的制备、感受态细胞的转化以及目的蛋白质gfp 的正常表达, 来完成一系列分子生物学基础实验。
通过本实验, 学习并掌握碱裂解法、双酶切、氯化钙法制备感受态细胞的制备及采用α互补现象进行重组DNA鉴定的原理和方法。
1.2 实验原理质粒是细菌内共生型遗传因子, 它能在细菌中垂直遗传并且赋予宿主细胞特定的表型, 经过改造的基因工程质粒是携带外源基因进入细菌中扩增或表达的重要媒介, 这种基因的运载工具在基因工程中具有极广泛的用途。
本次实验中, 分子克隆质粒载体T所携带的外源基因是gfp绿色荧光蛋白, 实验的最终目的是将gfp基因插入表达载体P中, 组成重组子, 并导入到大肠杆菌细胞中并诱导其表达, 培养出绿色的大肠杆菌菌落。
为此, 我们要利用碱变性法将大肠杆菌中的质粒DNA提取出来, 并通过HandⅢ和NCO Ⅰ两种酶的双酶切作用, 从而获得目的外源基因片段gfp和表达载体-P质粒的DNA, 然后通过连接酶连接后形成重组子, 并通过氯化钙法导入大肠杆菌感受态细胞中, 让其在含有Amp和IPTG的LB琼脂平板上生长繁殖, 最后通过观察大肠杆菌能否在含有Amp 和IPTG的LB平板上长出绿色的菌落, 来判断gfp基因工程菌的构建效果。
广东工业大学现代分子生物技术实验报告2 实验流程2.1 实验安排表实验内容时间安排质粒T、质粒P的提取 3 h电泳检测质粒提取效果30~45 min确定质粒提取成功后, 利用HindⅢ、NcoⅠ这2种限制性内10~11 h切酶分别对质粒T、质粒P进行双酶切电泳检测酶切情况, 若酶切成功, 利用试剂盒回收DNA片断45 min利用T4 DNA连接酶进行连接14~16 h大肠杆菌感受态细胞的制备 3 h转化(gfp基因导入受体细胞) 2 h 重组子的筛选(在含有Amp的LB平板上筛选)12~16 h诱导表达与鉴定(加入诱导物IPTG诱导gfp表达)12~16 h2.2 实验流程图①质粒DNA的提取与纯化碱液裂解法;乙醇洗涤纯化(T-gfp质粒作为克隆载体、P32作为表达载体)②通过观察电泳图片, 来鉴定T、P两种质粒DNA的提取结果琼脂糖凝胶电泳的方法③对成功提取的T、P两种质粒DNA进行双酶切限制性内切酶Han dⅢ、NcoⅠ④T-gfp、P两种质粒的DNA片段的回收割胶(试剂盒快速回收)用刀片把凝胶上的目的DNA条带割取下来3 实验操作方法⑤连接T-gfp、P两种质粒的目的DNA T4噬菌体DNA连接酶(重组DNA分子的构建)⑥大肠杆菌感受态细胞的制备氯化钙法⑦将连接后的重组DNA分子导入大肠杆菌感受态细胞感受态细胞的转化⑧重组子的筛选含有AMP r的重组子才能在AMP平板上生长⑨将含有gfp、AMP r两种目的基因的重组子进行诱导表达重组DNA分子的鉴定在平板上加入底物IPTGgfp绿色荧光蛋白基因被诱导表达⑩gfp基因只有在诱导物IPTG和底物X-gal的存在时, 才能正常表达, 在平板上生成绿色的菌落构建出含有gfp绿色荧光蛋白基因的工程菌图2.1 gfp基因工程菌的构建与表达广东工业大学现代分子生物技术实验报告3实验操作方法3.1 质粒DNA的提取3.1.1 实验概述1.分子克隆载体载体是指运载外源DNA有效进入受体细胞内的工具。

pUC18 pUC18大肠杆菌克隆载体基本信息:启动子: Lac/lac复制子: ColE1 ori质粒分类: 大肠杆菌载体;克隆质粒质粒大小: 2686bp质粒标签: LacZ原核抗性: 氨苄青霉素Amp克隆菌株: DH5α培养条件: 37℃,有氧,LB5'测序引物: M13F:TGTAAAACGACGGCCAGT 3'测序引物: M13R:CAGGAAACAGCTATGACCpUC18载体质粒图谱和多克隆位点信息:pUC18载体简介:pUC18是适合于双脱氧法DNA测序的载体,通常运用于重组dna的分子克隆中,首先我们制备大肠杆菌的感受态细胞(能接受外来重组的dna),这种感受态菌株必须不同外来DNA分子发生遗传重组,通常是rec基因缺陷型的突变体,同时它们必须是限制系统缺陷或限制与修饰系统均缺陷的菌株,即具有这三种缺陷(rk mk rec ),同时对氨苄青霉素敏感(ap)。
puc18载体自身带有抗氨苄青霉素基因,而外源片段不具有,这样只有带有puc18的转化子的菌株才能在氨苄青霉素平板上存活,而外源片段自身环化的不能存活,这称为抗性筛选。
pUC18 上带有β-半乳糖苷酶基因(lacZ)的调控序列和β-半乳糖苷酶N 端146 个氨基酸的编码序列,在这个编码区中插有一个多克隆位点,且不影响正常功能,DH5α感受态菌株带有β-半乳糖苷酶C 端部分序列的编码信息,当puc18载体在正常情况下同感受态菌株融合后,互补表达有活性的β-半乳糖苷酶,称为α-互补现象,当有外源片段插入多克隆位点后,不能产生互补,即细菌不能产生β-半乳糖苷酶活性。
在呈色底物X-gal(5-溴-4-氯-3-吲哚-β-半乳糖苷酶)和诱导物IPTG(异丙基-β-D-硫代半乳糖苷)的存在下,互补产物菌落呈现蓝色,不互补产物菌落呈白色,很容易鉴别,这种筛选方法称为α-互补现象筛选(蓝白斑筛选)。
由上可见,puc18载体除了能重组导入外源片段外,在筛选表达过程中还具有重要的作用pUC18载体序列:ORIGIN1 TCGCGCGTTT CGGTGATGAC GGTGAAAACC TCTGACACAT GCAGCTCCCG GAGACGGTCA61 CAGCTTGTCT GTAAGCGGAT GCCGGGAGCA GACAAGCCCG TCAGGGCGCG TCAGCGGGTG121 TTGGCGGGTG TCGGGGCTGG CTTAACTATG CGGCATCAGA GCAGATTGTA CTGAGAGTGC181 ACCATATGCG GTGTGAAATA CCGCACAGAT GCGTAAGGAG AAAATACCGC ATCAGGCGCC241 ATTCGCCATT CAGGCTGCGC AACTGTTGGG AAGGGCGATC GGTGCGGGCC TCTTCGCTAT301 TACGCCAGCT GGCGAAAGGG GGATGTGCTG CAAGGCGATT AAGTTGGGTA ACGCCAGGGT361 TTTCCCAGTC ACGACGTTGT AAAACGACGG CCAGTGCCAA GCTTGCATGC CTGCAGGTCG421 ACTCTAGAGG ATCCCCGGGT ACCGAGCTCG AATTCGTAAT CATGGTCATA GCTGTTTCCT481 GTGTGAAATT GTTATCCGCT CACAATTCCA CACAACATAC GAGCCGGAAG CATAAAGTGT541 AAAGCCTGGG GTGCCTAATG AGTGAGCTAA CTCACATTAA TTGCGTTGCG CTCACTGCCC601 GCTTTCCAGT CGGGAAACCT GTCGTGCCAG CTGCATTAAT GAATCGGCCA ACGCGCGGGG661 AGAGGCGGTT TGCGTATTGG GCGCTCTTCC GCTTCCTCGC TCACTGACTC GCTGCGCTCG721 GTCGTTCGGC TGCGGCGAGC GGTATCAGCT CACTCAAAGG CGGTAATACG GTTATCCACA781 GAATCAGGGG ATAACGCAGG AAAGAACATG TGAGCAAAAG GCCAGCAAAA GGCCAGGAAC841 CGTAAAAAGG CCGCGTTGCT GGCGTTTTTC CATAGGCTCC GCCCCCCTGA CGAGCATCAC 901 AAAAATCGAC GCTCAAGTCA GAGGTGGCGA AACCCGACAG GACTATAAAG ATACCAGGCG 961 TTTCCCCCTG GAAGCTCCCT CGTGCGCTCT CCTGTTCCGA CCCTGCCGCT TACCGGATAC 1021 CTGTCCGCCT TTCTCCCTTC GGGAAGCGTG GCGCTTTCTC AAAGCTCACG CTGTAGGTAT 1081 CTCAGTTCGG TGTAGGTCGT TCGCTCCAAG CTGGGCTGTG TGCACGAACC CCCCGTTCAG 1141 CCCGACCGCT GCGCCTTATC CGGTAACTAT CGTCTTGAGT CCAACCCGGT AAGACACGAC 1201 TTATCGCCAC TGGCAGCAGC CACTGGTAAC AGGATTAGCA GAGCGAGGTA TGTAGGCGGT 1261 GCTACAGAGT TCTTGAAGTG GTGGCCTAAC TACGGCTACA CTAGAAGAAC AGTATTTGGT 1321 ATCTGCGCTC TGCTGAAGCC AGTTACCTTC GGAAAAAGAG TTGGTAGCTC TTGATCCGGC 1381 AAACAAACCA CCGCTGGTAG CGGTGGTTTT TTTGTTTGCA AGCAGCAGAT TACGCGCAGA 1441 AAAAAAGGAT CTCAAGAAGA TCCTTTGATC TTTTCTACGG GGTCTGACGC TCAGTGGAAC 1501 GAAAACTCAC GTTAAGGGAT TTTGGTCATG AGATTATCAA AAAGGATCTT CACCTAGATC 1561 CTTTTAAATT AAAAATGAAG TTTTAAATCA ATCTAAAGTA TATATGAGTA AACTTGGTCT 1621 GACAGTTACC AATGCTTAAT CAGTGAGGCA CCTATCTCAG CGATCTGTCT ATTTCGTTCA 1681 TCCATAGTTG CCTGACTCCC CGTCGTGTAG ATAACTACGA TACGGGAGGG CTTACCATCT 1741 GGCCCCAGTG CTGCAATGAT ACCGCGAGAC CCACGCTCAC CGGCTCCAGA TTTATCAGCA 1801 ATAAACCAGC CAGCCGGAAG GGCCGAGCGC AGAAGTGGTC CTGCAACTTT ATCCGCCTCC 1861 ATCCAGTCTA TTAATTGTTG CCGGGAAGCT AGAGTAAGTA GTTCGCCAGT TAATAGTTTG 1921 CGCAACGTTG TTGCCATTGC TACAGGCATC GTGGTGTCAC GCTCGTCGTT TGGTATGGCT 1981 TCATTCAGCT CCGGTTCCCA ACGATCAAGG CGAGTTACAT GATCCCCCAT GTTGTGCAAA 2041 AAAGCGGTTA GCTCCTTCGG TCCTCCGATC GTTGTCAGAA GTAAGTTGGC CGCAGTGTTA 2101 TCACTCATGG TTATGGCAGC ACTGCATAAT TCTCTTACTG TCATGCCATC CGTAAGATGC 2161 TTTTCTGTGA CTGGTGAGTA CTCAACCAAG TCATTCTGAG AATAGTGTAT GCGGCGACCG 2221 AGTTGCTCTT GCCCGGCGTC AATACGGGAT AATACCGCGC CACATAGCAG AACTTTAAAA 2281 GTGCTCATCA TTGGAAAACG TTCTTCGGGG CGAAAACTCT CAAGGATCTT ACCGCTGTTG 2341 AGATCCAGTT CGATGTAACC CACTCGTGCA CCCAACTGAT CTTCAGCATC TTTTACTTTC 2401 ACCAGCGTTT CTGGGTGAGC AAAAACAGGA AGGCAAAATG CCGCAAAAAA GGGAATAAGG 2461 GCGACACGGA AATGTTGAAT ACTCATACTC TTCCTTTTTC AATATTATTG AAGCATTTAT 2521 CAGGGTTATT GTCTCATGAG CGGATACATA TTTGAATGTA TTTAGAAAAA TAAACAAATA 2581 GGGGTTCCGC GCACATTTCC CCGAAAAGTG CCACCTGACG TCTAAGAAAC CATTATTATC 2641 ATGACATTAA CCTATAAAAA TAGGCGTATC ACGAGGCCCT TTCGTC//pUC18其他相关大肠杆菌克隆载体:pUC57-KanpUC57-SimplepUC57pUC119pUC118pJET1.2 T RecombinedpMD-19T(Simple)pGEM-3Zf(+)pBluescript II SK(+)pBluescript II KS(+)pACYC184 pSP73 pACYC177 pUC19 pUC18 pBR322 pMD-18T。
分子克隆的步骤及原理基本原理克隆开始前至少需要两个重要的DNA分子。
首先,您需要要克隆的DNA片段,也称为插入片段。
它可以来自原核,真核,灭绝的生物,也可以在实验室中人工创造。
通过使用分子克隆,我们可以更多地了解特定基因的功能。
其次,你需要一个矢量。
载体是用作分子生物学工具的质粒DNA,用于制备更多拷贝或从某种基因产生蛋白质。
质粒是载体的一个例子,是由细菌复制的圆形,染色体外的DNA。
质粒通常具有多克隆位点或MCS,该区域含有不同限制性内切核酸酶的识别位点,也称为限制酶。
可以通过称为连接的技术将不同的插入物掺入质粒中。
载体质粒还含有复制起点,使其可以在细菌中复制。
另外,质粒具有抗生素基因。
如果细菌整合了质粒,它将在含有抗生素的培养基中存活。
这允许选择已经成功转化的细菌。
将插入物和载体克隆到宿主细胞的生物体中,最常用于分子克隆的是大肠杆菌。
大肠杆菌生长迅速,可广泛获得并且具有许多可商购的不同克隆载体。
真核生物,如酵母,也可用作载体生物。
一般分子克隆方法的第一步是获得所需的插入物,其可以来自任何细胞类型的DNA或mRNA。
然后根据插入物的类型选择最佳载体及其宿主生物,最终将用它完成。
聚合酶链式反应或基于PCR的方法通常用于复制插入物。
然后,使用一系列酶促反应,将消化插入物连接在一起并引入宿主生物体中以进行大量复制。
从细菌中纯化重复的载体,并在限制性消化后,在凝胶上分析。
然后将在凝胶上纯化的片段送去测序以验证该奖章是所需的DNA片段。
操作过程(1)DNA片段的制备:常用以下方法获得DNA片段:①用限制性核酸内切酶将高分子量DNA切成一定大小的DNA 片段;②用物理方法(如超声波)取得DNA随机片段;③在已知蛋白质的氨基酸顺序情况下,用人工方法合成对应的基因片段;④从mRNA反转录产生cDNA。
(2)载体DNA的选择:①质粒:质粒是细菌染色体外遗传因子,DNA呈环状,大小为1-200千碱基对(kb)。
在细胞中以游离超螺旋状存在,很容易制备。
大肠杆菌在分子生物学与生物技术中的应用大肠杆菌(Escherichia coli)是一种广泛存在于动物肠道中的杆菌。
由于其生长速度快、操作简便,以及其成熟的遗传学和基因工程技术,大肠杆菌成为了分子生物学和生物技术领域中的重要研究对象。
一、大肠杆菌在基因克隆中的应用大肠杆菌的遗传学研究始于20世纪40年代,随着现代分子生物学和基因工程技术的发展,大肠杆菌成为了最常用的基因克隆宿主。
大肠杆菌的基因组是一个圆形双链DNA分子,包含了约4,500个基因。
大肠杆菌的基因组大小适中,便于操作;并且绝大部分基因已经被注释,可以用于数据挖掘、基因分析和改造等应用。
在大肠杆菌中可以克隆各种带有启动子、编码区、反义密码子等功能区域的外来DNA分子,可以通过分子克隆技术的方法,将所需基因克隆到质粒或染色体上,进而实现目的基因的表达和功能研究。
二、大肠杆菌在表达蛋白的应用大肠杆菌是常用的表达蛋白宿主,可以通过在其基因组中插入外源基因,并将其发挥于目的蛋白的生产。
这是一种简单、高效的生产蛋白的方法。
大肠杆菌表达系统已成为工业化生产重要蛋白的主要方法之一。
目前,大肠杆菌表达体系主要分为原核和真核两类。
原核表达是指将外源基因插入质粒,导入大肠杆菌中进行表达。
真核表达是指将外源基因插入真核细胞质粒中,将其转化为蛋白,再将蛋白导入大肠杆菌中进行后续处理。
三、大肠杆菌在基因编辑和基因改造中的应用大肠杆菌作为常见的细胞工厂,在基因编辑和基因改造中发挥着重要的作用。
通过大肠杆菌的基因编辑,可以有效抑制或改变其特定的基因表达。
所谓基因编辑,是指通过介导靶向去除或替换基因片段,引发突变或修复突变,从而实现特定基因的功能破坏或修复。
使用大肠杆菌进行基因编辑的优点是:操作简单;高效性、不依赖于携带外界基因的载体;可靠性好、操作风险较低;适用于单个、多个或整个基因谱系的编辑。
四、大肠杆菌在制药领域中的应用大肠杆菌被广泛应用于生产制备各种生物制品,如抗生素、酶、质粒、疫苗、抗体和蛋白类产品等。
一、实验目的1. 熟悉载体构建的基本原理和操作步骤。
2. 掌握载体构建过程中各种试剂和仪器的使用方法。
3. 学习如何进行载体构建的鉴定和验证。
二、实验原理载体构建是基因工程中的重要环节,通过将目的基因插入到载体中,构建成具有特定功能的重组质粒。
本实验以大肠杆菌为宿主菌,采用常规分子克隆技术进行载体构建。
三、实验材料1. 载体:pUC19、pMD18-T载体2. 目的基因:PCR产物3. 试剂:DNA限制性内切酶、DNA连接酶、T4 DNA连接酶、dNTPs、Tris-HCl缓冲液、琼脂糖、氯化钠、SDS、甘油等4. 仪器:PCR仪、电泳仪、凝胶成像系统、离心机、超净工作台、恒温培养箱等四、实验步骤1. 酶切载体和目的基因a. 配制酶切反应体系:DNA模板(载体和目的基因)1μl,10×酶切缓冲液1μl,限制性内切酶10U,去离子水加至20μl。
b. 37℃水浴反应2-3小时。
2. 琼脂糖凝胶电泳鉴定酶切产物a. 配制琼脂糖凝胶电泳体系:1×TBE缓冲液50μl,琼脂糖0.5g,DNA模板10μl,加去离子水至100μl。
b. 100V电压电泳30分钟,观察酶切产物条带。
3. DNA连接a. 配制连接反应体系:酶切后的载体5μl,酶切后的目的基因5μl,10×连接缓冲液2μl,T4 DNA连接酶1μl,去离子水加至20μl。
b. 16℃连接过夜。
4. 转化a. 将连接产物加入感受态细胞(如大肠杆菌DH5α)中,冰浴30分钟。
b. 42℃热激45秒。
c. 立即加入冰浴2分钟。
d. 加入1ml SOC培养基,37℃培养1小时。
5. 鉴定转化子a. 取100μl转化后的菌液,涂布于含有抗生素的琼脂糖平板上。
b. 37℃恒温培养过夜。
c. 观察菌落,选取白色菌落进行PCR鉴定。
6. PCR鉴定a. 配制PCR反应体系:DNA模板1μl,10×PCR缓冲液2μl,上下游引物各1μl,dNTPs 0.5μl,Taq DNA聚合酶1U,去离子水加至20μl。